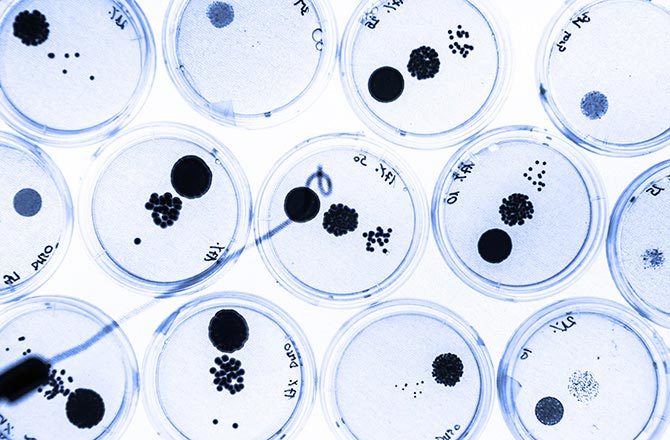
{keywords}

Biết chắc chắn bản thân một ngày nào đó sẽ từ giã trần thế, nhiều người lựa chọn được chôn cất khi qua đời. Số khác muốn được hỏa táng hoặc thậm chí đưa hài cốt của họ vào không gian.
Tất cả các phương pháp trên dường như không mang lại nhiều lợi ích cho những người ở lại. Tuy nhiên, việc chọn hiến tặng cơ thể cho khoa học có thể đảm bảo một người vẫn tiếp tục cống hiến cho xã hội ngay cả khi đã chết. Vậy điều gì sẽ xảy ra với xác người được hiến tặng?

Ở Mỹ, luật pháp và các tiêu chuẩn trong ngành công nghiệp đều đưa ra các hướng dẫn về thực hành và nguyên tắc xử thế đối với "món quà giải phẫu học". Một khi xác được hiến tặng cho khoa học, người hiến tặng thường không có yêu cầu về cách tử thi sẽ được sử dụng như thế nào, mặc dù một số ít các cơ quan vẫn tôn trọng những yêu cầu của họ, nếu có. Các thi thể sẽ được phân chia theo nhu cầu nghiên cứu và thị trường.
Một khi xác hiến tặng ở trong tay của các chuyên gia nghiên cứu hoặc chuyên gia y tế, chúng có khả năng được sử dụng cho nhiều mục đích khoa học khác nhau.

Theo Thư viện Y học quốc gia Mỹ, một người hiến tặng các cơ quan nội tạng và mô của mình có thể cứu sống hoặc cải thiện cuộc sống của tới 50 người khác. Các cơ quan nội tạng có thể được lưu trữ sau khi người chết bao gồm các quả thận, trái tim, phổi, tuyến tụy, ruột, da, giác mạc, ...
Trang OrganDonor.gov thống kê rằng, năm 2013, 28.954 người đã được cấy ghép nội tạng hiến tặng. Mỗi ngày, trung bình có 79 người trải qua quá trình này. Và trung bình mỗi ngày có 21 người cần được cấy ghép bộ phận cơ thể đã chết trong khi chờ đợi người hiến tặng phù hợp.

Các bác sĩ tương lai đều được đào tạo trong các trường y. Việc giải phẫu một tử thi lần đầu tiên là nghi thức nhập môn bắt buộc từ lâu đối với các sinh viên trường y. Đặc biệt, trong vài năm học đầu tiên, họ học môn giải phẫu học không chỉ thông qua sách vở, mà còn qua việc giải phẫu và xem xét các tử thi.
Các bác sĩ phẫu thuật, từ những chuyên gia tim mạch đến chuyên gia thẩm mỹ, cũng học và thực hành những kỹ thuật mới thông qua sử dụng xác chết.

Các chuyên gia pháp y có thể sử dụng xác hiến tặng để nghiên cứu ra cách truy bắt kẻ giết người. Họ nghiên cứu về quá trình phân hủy xác để hỗ trợ các điều tra viên xác định thời gian và nguyên nhân cái chết.

Nếu bạn thích các bảo tàng, bạn có thể hiến tặng xác cho những cơ sở này để trưng bày. Có lẽ, việc sử dụng tử thi trong bảo tàng nổi tiếng nhất là cuộc triển lãm Body Worlds ở thành phố New York, Mỹ.
Là sản phẩm sáng tạo của nhà giải phẫu Gunther von Hagens, mỗi thi thể trưng bày đã trải qua một quá trình nhựa hóa, trong đó mỗi tế bào đơn lẻ được bảo quản trong silicone. Các cơ quan nội tạng, mô và hệ thống bên trong cơ thể đều rõ thấy vì cả 25 cơ thể toàn vẹn được trưng bày, đều đã bị loại bỏ hết lớp da.
Xác do những người chết vì các bệnh nan y hiến tặng có thể cung cấp cơ hội nghiên cứu vô giá cho khoa học, tiềm ẩn khả năng cứu sống vô số những người mắc cùng chứng bệnh đó trong tương lai.
Các nghiên cứu trên xác hiến tặng đã dẫn tới nhiều tiến bộ trong việc phòng và điều trị nhiều căn bệnh, không chỉ giới hạn ở bệnh tim, tiểu đường, bệnh Alzheimer hay nhiều chứng ung thư khác nhau. Những người hiến xác cũng có thể đóng góp cho nghiên cứu về các bệnh mạn tính, chẳng hạn như viêm khớp, loãng xương hay vẹo xương sống.

Các hãng xe đang cố gắng cải tiến độ an toàn sản phẩm của họ cũng thường sử dụng người nộm để mô phỏng các ảnh hưởng của va chạm giao thông. Họ cũng sử dụng cả xác người hiến tặng để kiểm nghiệm sự hữu ích của các tính năng mới trang bị cho xe, do dữ liệu thu được đầy đủ và đáng tin cậy hơn so với kiểm nghiệm bằng người nộm và phần mềm mô phỏng.
Theo những người trong nghề, việc kiểm nghiệm bằng tử thi có thể cung cấp chi tiết cách một va chạm có thể gây ra với các cơ quan nội tạng và mô mềm, do việc giải phẫu tử thi sau va chạm hé lộ mức độ tổn thương từ sự cố đó. Các hãng xe hơi không sẵn lòng thừa nhận hoặc tham gia trực tiếp vào việc dùng tử thi thử nghiệm sản phẩm. Thay vào đó, họ thường tài trợ cho các trường đại học hoặc tổ chức nghiên cứu tiến hành thử nghiệm và thu nhận, ứng dụng các kết quả sau đó.

Trong quá trình phát triển tàu vũ trụ Orion chuyên chở con người vào không gian, các nhà thầu của Cơ quan hàng không vũ trụ Mỹ (NASA) cũng sử dụng 3 tử thi của người để kiểm nghiệm mẫu trang phục du hành, ghế ngồi và các hệ thống hạ cánh của tàu.

Các binh lính khi làm nhiệm vụ có thể đối mặt với đủ loại nguy hiểm đe dọa đến tính mạng. Các nghiên cứu của quân đội sử dụng xác hiến tặng có thể giúp cải tiến và đảm bảo an toàn cho các trang thiết bị của họ, chẳng hạn như áp giáp.
Tuy nhiên, việc sử dụng xác người cho nghiên cứu quân sự từng dẫn đến tranh cãi. Chẳng hạn như năm 2003, Trường Y thuộc Đại học Tulane (Mỹ) từng khám phá ra rằng, 7 tử thi họ cung cấp cho lục quân Mỹ đã được dùng trong các thử nghiệm bom mìn để kiểm tra giày bảo vệ của các binh sĩ. Vì sự cố này, Đại học Tulane đã ngừng quan hệ với một công ty dịch vụ giải phẫu sau đó.
Tuấn Anh (Theo Discovery)